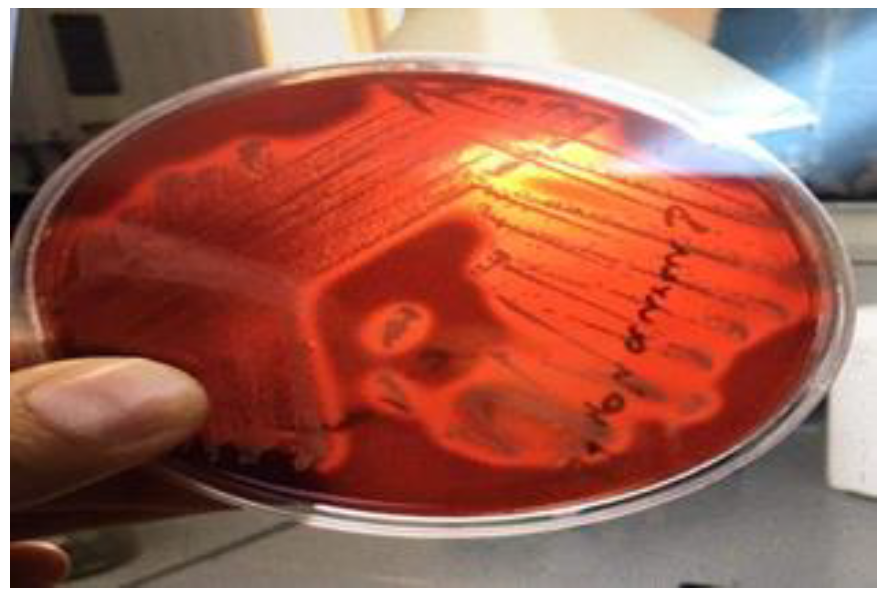
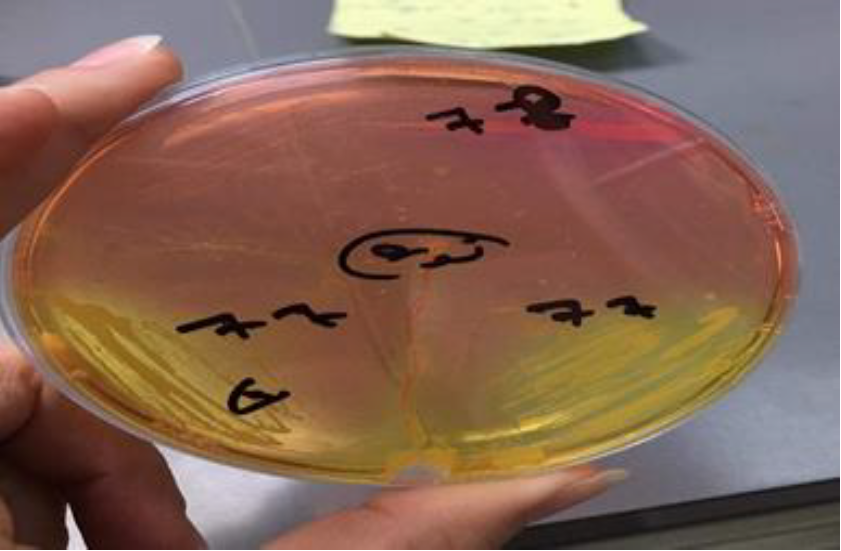
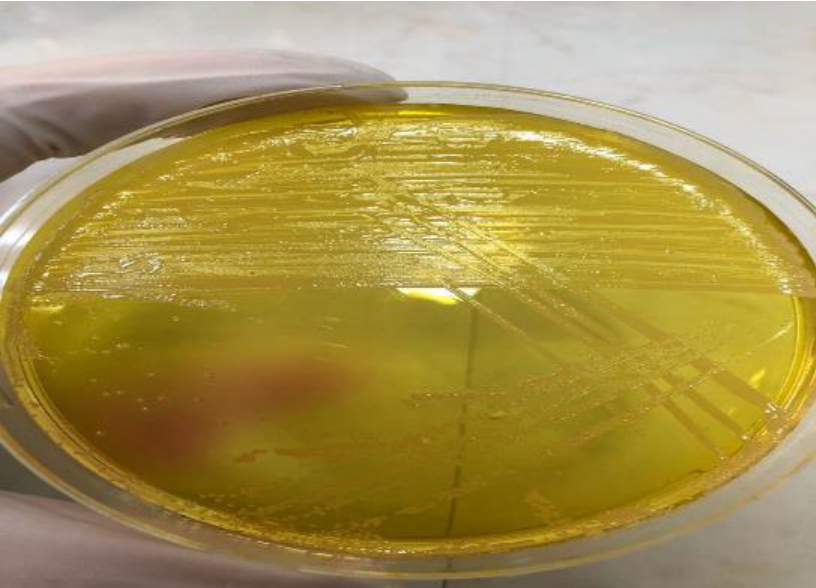

Peyrani, P. et al. “The Burden of Community-Acquired Bacterial Pneumonia in the Era of Antibiotic Resistance.” Expert Review of Respiratory Medicine, vol. 13, no. 2, 2019, pp. 139–152. https://doi.org/10.1080/17476348.201 9.1562339
Singh, R. et al. “Antibiotic Resistance in Major Rivers in the World: A Systematic Review on Occurrence, Emergence and Management Strategies.” Journal of Cleaner Production, vol. 234, 2019, pp. 1484–1505. https://doi.org/10.1016/j.jclepro.2019.06.196
Wang, Y. et al. “Antibiotic-Free Antibacterial Strategies Enabled by Nanomaterials: Progress and Perspectives.” Advanced Materials, vol. 32, no. 18, 2020, article 1904106. https://doi.org/10.1002/adma.201904106
Christaki, E. et al. “Antimicrobial Resistance in Bacteria: Mechanisms, Evolution and Persistence.” Journal of Molecular Evolution, vol. 88, no. 1, 2020, pp. 26–40. https://doi.org/10.1007/s00239-019-09914-3
Bakkeren, E. et al. “Evolutionary Causes and Consequences of Bacterial Antibiotic Persistence.” Nature Reviews Microbiology, vol. 18, no. 9, 2020, pp. 479–490. https:/ /doi.o rg/10.10 38/s41579-020-0378-z
Araújo, G. R. et al. “The Mechanical Properties of Microbial Surfaces and Biofilms.” The Cell Surface, vol. 5, 2019, article 100028. https://doi.org/10.1016/j.tcsw.2019.100028
Tytgat, H. L. P. et al. “Bowel Biofilms: Tipping Points between a Healthy and Compromised Gut?” Trends in Microbiology, vol. 27, no. 1, 2019, pp. 17–25. https://doi.org/10.1016/j.tim.2018.08.011
Mottola, C. et al. “Susceptibility Patterns of Staphylococcus aureus Biofilms in Diabetic Foot Infections.” BMC Microbiology, vol. 16, 2016, article 1–9. https://doi.org/10. 1186/s12866-016-0680-6
Yin, W. et al. “Ways to Control Harmful Biofilms: Prevention, Inhibition and Eradication.” Critical Reviews in Microbiology, vol. 47, no. 1, 2021, pp. 57–78. https://doi.org/10.1080/1040841X.2020.1843431
Abushaheen, M. A. et al. “Antimicrobial Resistance, Mechanisms and Its Clinical Significance.” Disease-a-Month, vol. 66, no. 6, 2020, article 100971. https://doi.org/10.1016/j.disamonth.2020.100971
Walther, B. A. et al. “Biodiversity and Health: Lessons and Recommendations from an Interdisciplinary Conference.” Infection, Genetics and Evolution, vol. 40, 2016, pp. 29–46. https://doi.org/10.1016/j.meegid.2016.02.003
Ghareeb, O. A. “Hepato-Renal Dysfunctions Induced by Gold Nanoparticles and Preservative Efficacy of Black Seed Oil.” Journal of Medicinal and Chemical Sciences, vol. 5, no. 1, 2022, pp. 137–143.
Ramadhan, S. A. and O. A. Ghareeb. “Efficiency of Cichorium intybus in Reducing Hepatotoxicity Induced by Zinc Oxide Nanoparticles.” Annals of Medical and Health Sciences Research, vol. 12, no. 3, 2022, pp. 93–96.
Kolayli, S. and M. Keskin. “Natural Bee Products and Their Apitherapeutic Applications.” Studies in Natural Products Chemistry, vol. 66, 2020, pp. 175–196. https://doi.org/ 10.1016/B978-0-444-64328-0.00006-7
Saranraj, P. et al. “Pharmacology of Honey: A Review.” Advances in Biological Research, vol. 10, no. 4, 2016, pp. 271–289.
Szweda, P. “Antimicrobial Activity of Honey.” Honey Analysis, vol. 3, 2017, pp. 15–25. https://doi.or g/10.1007/978-3-319-65755-4_2
Abbas, H. A. “Comparative Antibacterial and Antibiofilm Activities of Manuka Honey and Egyptian Clover Honey.” Asian Journal of Applied Sciences, vol. 2, no. 2, 2014.
Zulkhairi Amin, F. A. et al. “Therapeutic Properties of Stingless Bee Honey in Comparison with European Bee Honey.” Advances in Pharmacological Sciences, 2018, article ID 6179596. https://doi.org/10.1 155/2018/6179596
Yupanqui Mieles, J. et al. “Honey: An Advanced Antimicrobial and Wound Healing Biomaterial for Tissue Engineering Applications.” Pharmaceutics, vol. 14, no. 8, 2022, article 1663. https://doi.org/10.3390/phar maceutics14081663
Kwakman, P. H. S. and S. A. J. Zaat. “Antibacterial Components of Honey.” IUBMB Life, vol. 64, no. 1, 2012, pp. 48–55. https://doi.org/10.1002/iub.578
Albaridi, N. A. “Antibacterial Potency of Honey.” International Journal of Microbiology, 2019, article ID 2464507. https://doi.org/10.1155/2019/2464507
Almasaudi, S. “The Antibacterial Activities of Honey.” Saudi Journal of Biological Sciences, vol. 28, no. 4, 2021, pp. 2188–2196. https://doi.org/10.1016/j.sjbs.2020.10.017
Ng, W. J. et al. “Antioxidant Properties and Inhibitory Effects of Trigona Honey against Staphylococcus aureus.” GEOMATE Journal, vol. 13, no. 37, 2017, pp. 28–33.
Lutpiatina, L. et al. “Inhibition of Propolis and Trigona spp. Honey towards MRSA and VRSA.” Indian Journal of Public Health Research & Development, vol. 9, no. 10, 2018.
Al-Kafaween, M. A. et al. “Pseudomonas aeruginosa and Streptococcus pyogenes Exposed to Malaysian Trigona Honey In Vitro.” Iranian Journal of Biotechnology, vol. 18, no. 4, 2020, article e2542. https://doi.or g/10.30498/ijb.2020.140450
Ashritha, M. “Comparative Analysis on the Antimicrobial Action of Honey, Orange Peel and Chlorhexidine.” Natural Volatiles & Essential Oils, vol. 8, no. 5, 2021, pp. 5978–5988.